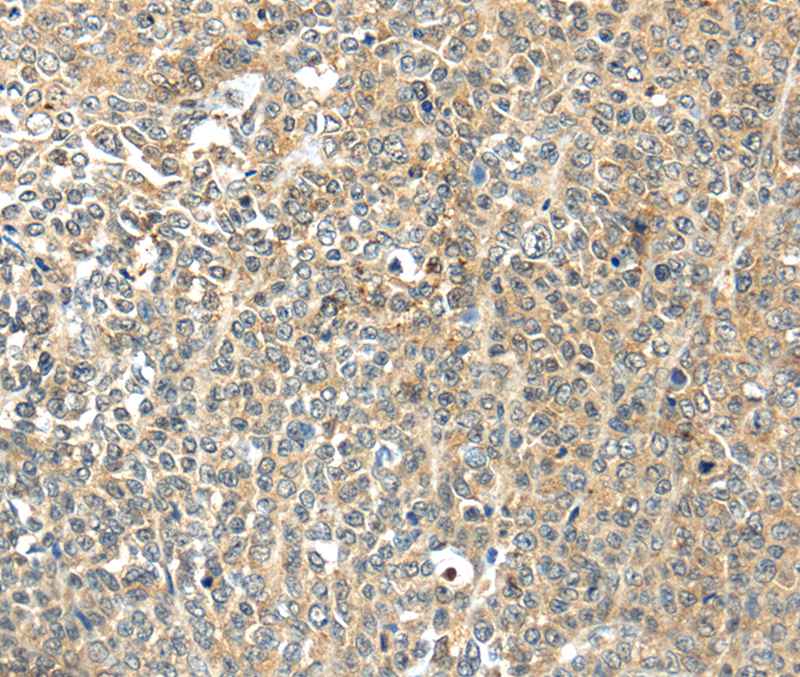
Anti-TSPYL6 Antibody

Immunohistochemistry analysis in human testis and endometrium tissues using Anti-TSPYL6 antibody. Corresponding TSPYL6 RNA-seq data are presented for the same tissues.
Anti-TSPYL6 Antibody
HPA034699
ApplicationsImmunoCytoChemistry, ImmunoHistoChemistry
Product group Antibodies
ReactivityHuman
TargetTSPYL6
Overview
- SupplierAtlas Antibodies
- Product NameAnti-TSPYL6 Antibody
- Delivery Days Customer4
- ApplicationsImmunoCytoChemistry, ImmunoHistoChemistry
- CertificationResearch Use Only
- ClonalityPolyclonal
- ConjugateUnconjugated
- Gene ID388951
- Target nameTSPYL6
- Target descriptionTSPY like 6
- Target synonymstestis-specific Y-encoded-like protein 6, TSPY-like protein 6, testicular tissue protein Li 211
- HostRabbit
- IsotypeIgG
- Protein IDQ8N831
- Protein NameTestis-specific Y-encoded-like protein 6
- Scientific DescriptionRecombinant Protein Epitope Signature Tag (PrEST) antigen sequence
- ReactivityHuman
- Storage Instruction-20°C,2°C to 8°C
- UNSPSC41116161